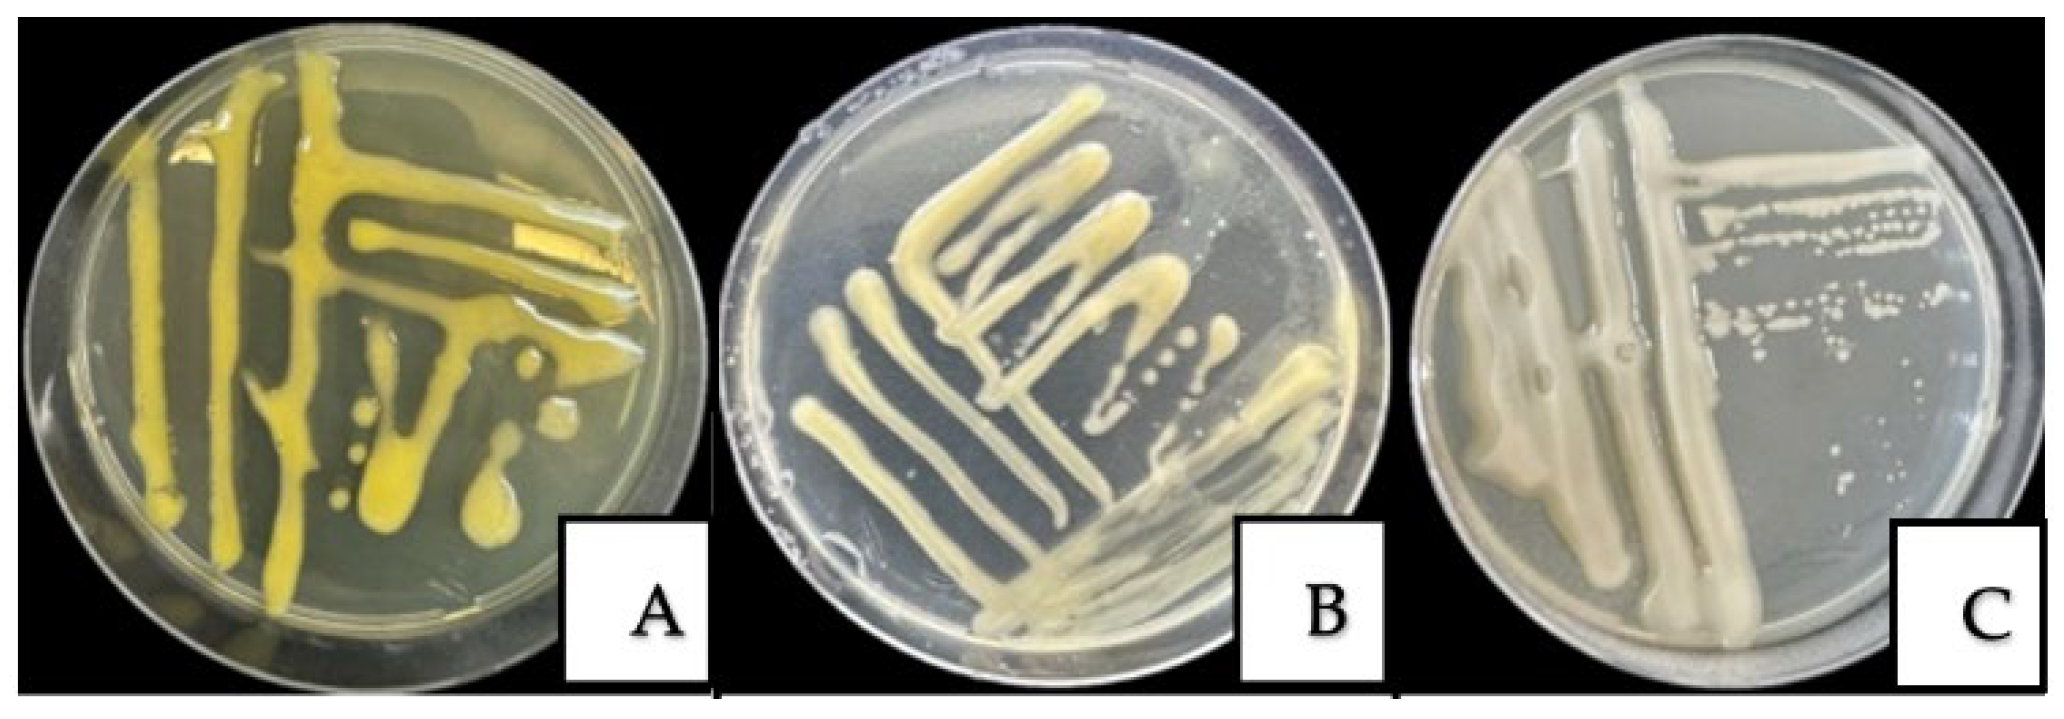
Horticulturae 11 01217 g004

Identification, Characterization, and Pathogenicity of Fungal and Bacterial Pathogens of Walnut (Juglans regia L.) in Kazakhstan
Abstract
1. Introduction
2. Materials and Methods
2.1. Location and Plant Materials
2.2. Disease Evaluation
2.3. Isolation of Pathogens from Infected Walnut Trees
2.4. Isolation of Pure Cultures of Fungi and Bacteria
2.5. Genomic DNA Extraction from Walnut Samples
2.6. Sequencing of ITS and 16S rRNA
2.7. Pathogenicity Tests
3. Results
3.1. Disease Identification
3.2. Morphological and Cultural Characteristics of Fungal and Bacterial Pathogens
3.3. Molecular Identification of Pathogens
3.4. Pathogenicity Tests for Fungal and Bacterial Isolates
3.4.1. Pathogenicity Tests for Fungal Isolates
3.4.2. Pathogenicity Tests of Bacterial Isolates
4. Discussion
5. Conclusions
Supplementary Materials
Author Contributions
Funding
Data Availability Statement
Acknowledgments
Conflicts of Interest
Abbreviations
| ITS | Internal Transcribed Spacer |
| DI | Disease incidence |
| DSI | Disease severity index |
References
- Kairova, G.; Taskuzhina, A.; Yanin, K.; Ismagulova, E.; Oleichenko, S.; Sarshayeva, M.; Sapakhova, Z.; Gritsenko, D. First Evaluation of Genetic Diversity and Population Structure of Wild and Cultivated Juglans regia in Kazakhstan. Genet. Resour. Crop Evol. 2025, 72, 8281–8292. [Google Scholar] [CrossRef]
- Sharma, M.; Sharma, M.; Sharma, M. A Comprehensive Review on Ethnobotanical, Medicinal and Nutritional Potential of Walnut (Juglans regia L.). Proc. Indian Natl. Sci. Acad. USA 2022, 88, 601–616. [Google Scholar] [CrossRef]
- Pollegioni, P.; Woeste, K.; Chiocchini, F.; Del Lungo, S.; Ciolfi, M.; Olimpieri, I.; Tortolano, V.; Clark, J.; Hemery, G.E.; Mapelli, S.; et al. Rethinking the History of Common Walnut (Juglans regia L.) in Europe: Its Origins and Human Interactions. PLoS ONE 2017, 12, e0172541. [Google Scholar] [CrossRef]
- Nurzhuma, M.; Kokhmetova, A.; Kumarbayeva, M.; Keishilov, Z.; Bakhytuly, K.; Bolatbekova, A.; Mukhametzhanov, K.; Akan, K. Assessment of Genetic Diversity in Walnut (Juglans regia L.) Genotypes from Southern and Southeastern Kazakhstan Using Microsatellite Markers. Horticulturae 2025, 11, 810. [Google Scholar] [CrossRef]
- Sapakhova, Z.; Kanat, R.; Choi, K.; Daurov, D.; Daurova, A.; Zhambakin, K.; Shamekova, M. CRISPR-Cas Gene Editing Technology in Potato. Int. J. Mol. Sci. 2025, 26, 7496. [Google Scholar] [CrossRef]
- Wang, X.; Li, K.; Han, M.; Zhang, W.; Li, X.; Ma, D.; Wang, F.; Pang, M.; Qi, J. Isolation and Identification of Endophytic Fungi in Walnut. IOP Conf. Ser. Earth Environ. Sci. 2020, 508, 012138. [Google Scholar] [CrossRef]
- Wang, S.; Tan, Y.; Li, S.; Zhu, T. Structural and Dynamic Analysis of Leaf-Associated Fungal Community of Walnut Leaves Infected by Leaf Spot Disease Based Illumina High-Throughput Sequencing Technology. Pol. J. Microbiol. 2022, 71, 429–441. [Google Scholar] [CrossRef]
- Zhu, Y.F.; Yin, Y.F.; Qu, W.W.; Yang, K.Q. Occurrence and Spread of the Pathogens on Walnut (Juglans regia) In Shandong Province, China. Acta Hortic. 2014, 1050, 347–351. [Google Scholar] [CrossRef]
- Belisario, A.; Forti, E.; Corazza, L.; van Kesteren, H.A. First Report of Alternaria alternata Causing Leaf Spot on English Walnut. Plant Dis. 1999, 83, 696. [Google Scholar] [CrossRef] [PubMed]
- Liu, Z.; Zhang, R.; Sun, D.; Tuerdi, M.; Zhu, T.; Chen, X. Alternaria alternata Causing Brown Spot Disease on Walnut in Xinjiang, China. Plant Dis. 2023, 107, 2224. [Google Scholar] [CrossRef]
- Vasić, T.; Jevremović, D.; Živković, S.; Leposavić, A.; Paunović, S. Morphological and Pathogenic Characteristic of Alternaria alternata Isolates on Walnut. J. Mt. Agric. Balk. 2021, 24, 224–238. [Google Scholar]
- Raina, A.; Kaul, S.; Sharma, I.; Khataia, K.; Dhar, M.K. First Report of Alternaria Alternata Causing Leaf Spot on Juglans regia in India. Plant Dis. 2025, 109, 1179. [Google Scholar] [CrossRef]
- Moya-Elizondo, E.A.; Lagos, M.J.; San Martin, J.; Ruiz, B. First Report of Alternaria alternata and Fusarium spp. Causing Brown Apical Necrosis in Walnut Fruit in Southern Chile. Plant Health Prog. 2021, 22, 573–574. [Google Scholar] [CrossRef]
- Seta, S.; Gonzalez, M.; Lori, G. First Report of Walnut Canker Caused by Fusarium incarnatum in Argentina. Plant Pathol. 2004, 53, 248. [Google Scholar] [CrossRef][Green Version]
- Singh, B.; Kalha, C.S.; Razdan, V.K. First Report of Walnut Canker Caused by Fusarium incarnatum in India. Plant Dis. 2011, 95, 1587. [Google Scholar] [CrossRef]
- Belisario, A.; Luongo, L.; Vitale, S.; Santori, A. First report of Fusarium semitectum as the agent of twig cankers on Persian (English) walnut in Italy. Plant Diseas. 2010, 94, 791. [Google Scholar] [CrossRef]
- An, X.-H.; Wang, N.; Wang, H.; Li, Y.; Si, X.-Y.; Zhao, S.; Tian, Y. Physiological and Transcriptomic Analyses of Response of Walnuts (Juglans regia) to Pantoea agglomerans Infection. Front. Plant Sci. 2023, 14, 1294643. [Google Scholar] [CrossRef] [PubMed]
- Xiao, J.; Liu, Z.; Sun, S.; Fan, C.; Wang, D.; Zhang, D. Complete Genome Sequence of Pantoea agglomerans CHTF15, a Walnut Pathogen. Mol. Plant-Microbe Interact. 2023, 36, 134–137. [Google Scholar] [CrossRef] [PubMed]
- Mulrean, E.N. Brown Apical Necrosis of Persian (English) Walnut Fruit. Phytopathology 1982, 72, 434. [Google Scholar] [CrossRef]
- Vauterin, L.; Hoste, B.; Kersters, K.; Swings, J. Reclassification of Xanthomonas. Int. J. Syst. Bacteriol. 1995, 45, 472–489. [Google Scholar] [CrossRef]
- Burokiene, D.; Pulawska, J. Bacterial blight of walnut (Juglans regia) caused by Xanthomonas arboricola pv. juglandis in Lithuania. J. Plant Pathol. 2012, 94, S1.43–S1.48. [Google Scholar]
- Bandi, A.; Kámán-Tóth, E.; Kolozsváriné Nagy, J.; Hevesi, M. Characterisation of Xanthomonas arboricola pv. juglandis strains from Hungary and Romania. Acta Microbiol. Immunol. Hung. 2014, 61, 121–135. [Google Scholar] [CrossRef]
- Kim, H.S.; Cheon, W.; Lee, Y.; Kwon, H.-T.; Seo, S.-T.; Balaraju, K.; Jeon, Y. Identification and characterization of Xanthomonas arboricola pv. juglandis causing bacterial blight of walnuts in Korea. Plant Pathol. J. 2021, 37, 137–151. [Google Scholar] [CrossRef]
- Pardatscher, R.; Gualandri, V.; Rizza, C.; Martini, M. First report of Xanthomonas arboricola pv. juglandis causing bacterial blight on walnut in Northern Italy. J. Plant Pathol. 2019, 101, 447. [Google Scholar]
- Kałużna, M.; Puławska, J.; Janse, J.D.; Young, J.M.; Sobiczewski, P. Genetic diversity and pathogenicity of Xanthomonas arboricola pv. juglandis strains isolated from walnut trees in Poland. Plant Pathol. 2021, 70, 842–857. [Google Scholar] [CrossRef]
- Iličić, R.; Popović, T.; Lalošević, V.; Jelušić, A. Association of Xanthomonas arboricola pv. juglandis with vertical oozing canker of walnut in Serbia. Plants 2021, 10, 2109. [Google Scholar] [CrossRef]
- Moragrega, C.; Llorente, I. Effects of leaf wetness duration, temperature, and host phenological stage on infection of walnut by Xanthomonas arboricola pv. juglandis. Plants 2023, 12, 2800. [Google Scholar] [CrossRef]
- Chorolque, F.; Orellana, R.; Alvarado, I.; Vignolo, G.; Stefani, E. Susceptibility of Chandler and Franquette walnut cultivars to Xanthomonas arboricola pv. juglandis under different climatic conditions in Argentina. J. Plant Pathol. 2024, 106, 45–56. [Google Scholar]
- Latinović, J.; Latinović, N.; Kandić, B.; Jelušić, A.; Popović Milovanović, T. Evidence and characterisation of Xanthomonas arboricola pv. juglandis causing bacterial blight of walnut in Montenegro. Plant Prot. Sci. 2025, 61, 255–261. [Google Scholar] [CrossRef]
- Rouhrazi, K.; Rahimian, H. Biochemical and genetic characterisation of Agrobacterium tumefaciens the causal agent of walnut crown gall disease in Iran. Arch. Phytopathol. Plant Prot. 2014, 47, 2493–2500. [Google Scholar] [CrossRef]
- Yakabe, L.E.; Parker, S.R.; Kluepfel, D.A. Role of systemic Agrobacterium tumefaciens populations in crown gall incidence on the walnut hybrid rootstock ‘Paradox’. Plant Dis. 2012, 96, 1415–1421. [Google Scholar] [CrossRef]
- Eshbekova, G.; Ismailov, Z. Isolation and characterization of Agrobacterium tumefaciens isolated from walnut (Juglans regia L.) Crown gall in selected region of Uzbekistan. In Innovations in Sustainable Agricultural Systems, Agriculture 4.0 and Precision Agriculture, Volume 2; Springer: Cham, Switzerland, 2025. [Google Scholar]
- Poret-Peterson, A.T.; Bhatnagar, S.; McClean, A.E.; Kluepfel, D.A. Draft genome sequence of Agrobacterium tumefaciens biovar 1 strain 186, isolated from walnut. Genome Announc. 2017, 5, e01232-17. [Google Scholar] [CrossRef]
- Kairova, M.; Yegizbayeva, T.K.; Yausheva, T.V.; Oleichenko, S.N.; Apushev, A.K. Biological properties of walnut genotypes in Kazakhstan. Syst. Rev. Pharm. 2020, 11, 932–940. [Google Scholar]
- Akça, Y.; Yuldaşulu, Y.B.; Murad, E.; Vahdati, K. Exploring of Walnut Genetic Resources in Kazakhstan and Evaluation of Promising Selections. Int. J. Hortic. Sci. Technol. 2020, 7, 93–102. [Google Scholar] [CrossRef]
- Xie, Z.; Li, M.; Wang, D.; Wang, F.; Shen, H.; Sun, G.; Feng, C.; Wang, X.; Chen, D.; Sun, X. Biocontrol Efficacy of Bacillus Siamensis LZ88 against Brown Spot Disease of Tobacco Caused by Alternaria alternata. Biol. Control 2021, 154, 104508. [Google Scholar] [CrossRef]
- Jiang, C.-H.; Wu, F.; Yu, Z.-Y.; Xie, P.; Ke, H.-J.; Li, H.-W.; Yu, Y.-Y.; Guo, J.-H. Study on Screening and Antagonistic Mechanisms of Bacillus amyloliquefaciens 54 against Bacterial Fruit Blotch (BFB) Caused by Acidovorax avenae subsp. citrulli. Microbiol. Res. 2015, 170, 95–104. [Google Scholar] [CrossRef]
- Khan, M.A. Laboratory Guide for Bacterial Plant Pathology; Pakistan Phytopathological Society: Faisalabad, Pakistan, 2020. [Google Scholar] [CrossRef]
- Murray, M.G.; Thompson, W.F. Rapid isolation of high molecular weight plant DNA. Nucleic Acids Res. 1980, 8, 4321–4326. [Google Scholar] [CrossRef] [PubMed]
- Sambrook, J.; Russell, D.W. Molecular Cloning: A Laboratory Manual, 3rd ed.; Cold Spring Harbor Laboratory Press: New York, NY, USA, 2001. [Google Scholar]
- Weisburg, W.G.; Barns, S.M.; Pelletier, D.A.; Lane, D.J. 16S Ribosomal DNA Amplification for Phylogenetic Study. J. Bacteriol. 1991, 173, 697–703. [Google Scholar] [CrossRef]
- Muyzer, G.; De Waal, E.C.; Uitterlinden, A.G. Profiling of Complex Microbial Populations by Denaturing Gradient Gel Electrophoresis Analysis of Polymerase Chain Reaction-Amplified Genes Coding for 16S rRNA. Appl. Environ. Microbiol. 1993, 59, 695–700. [Google Scholar] [CrossRef]
- White, T.J.; Bruns, T.; Lee, S.; Taylor, J. Amplification and Direct Sequencing of Fungal Ribosomal RNA Genes for Phylogenetics. In PCR Protocols; Elsevier: Amsterdam, The Netherlands, 1990; pp. 315–322. ISBN 978-0-12-372180-8. [Google Scholar]
- Ma, T.; Yang, C.; Cai, F.; Osei, R. Molecular Identification and Characterization of Fusarium Associated with Walnut Branch Blight Disease in China. Pathogens 2023, 12, 970. [Google Scholar] [CrossRef] [PubMed]
- Deng, Y.Z.; Qu, Z.; He, Y.; Naqvi, N.I. Sorting Nexin Snx41 Is Essential for Conidiation and Mediates Glutathione-Based Antioxidant Defense during Invasive Growth in Magnaporthe Oryzae. Autophagy 2012, 8, 1058–1070. [Google Scholar] [CrossRef]
- Yang, H.; Cao, G.; Jiang, S.; Han, S.; Yang, C.; Wan, X.; Zhang, F.; Chen, L.; Xiao, J.; Zhu, P.; et al. Identification of the anthracnose fungus of walnut (Juglans spp.) and resistance evaluation through physiological responses of resistant vs. susceptible hosts. Plant Pathol. 2021, 70, 1219–1229. [Google Scholar] [CrossRef]
- Zabiák, A.; Kovács, C.; Takács, F.; Pál, K.; Peles, F.; Fekete, E.; Karaffa, L.; Mihály, K.; Flipphi, M.; Sándor, E. Diaporthe and Diplodia species associated with walnut (Juglans regia L.) in Hungarian orchards. Horticulturae 2023, 9, 205. [Google Scholar] [CrossRef]
- Antony, S.; Billones-Baaijens, R.; Steel, C.; Stodart, J.; Savocchia, S. Pathogenicity and progression of Botryosphaeriaceae associated with dieback in walnut orchards in Australia. Eur. J. Plant Pathol. 2024, 168, 723–742. [Google Scholar] [CrossRef]
- Agrios, G.N. Plant Pathology, 5th ed.; Elsevier Academic Press: Amsterdam, The Netherlands, 2008; ISBN 978-0-12-044565-3. [Google Scholar]
- Wang, D.; Li, R.; Gao, G.; Jiakula, N.; Toktarbek, S.; Li, S.; Ma, P.; Feng, Y. Impact of climate change on food security in Kazakhstan. Agriculture 2022, 12, 1087. [Google Scholar] [CrossRef]
- Noh, Y.-H.; Cha, J.S. Xanthomonas arboricola pv. juglandis str. NCPPB 1447 Genome Sequencing. 2012. Available online: https://www.ncbi.nlm.nih.gov/datasets/genome/GCF_000306055.1/ (accessed on 7 August 2025).
- Simmons, E.G. Alternaria: An Identification Manual; CBS Fungal Biodiversity Centre: Utrecht, The Netherlands, 2007. [Google Scholar]
- Olson, W.H.; Buchner, R.P.; Adaskaveg, J.E.; Lindow, S.E. Walnut Blight Control in California. Acta Hortic. 1997, 442, 361–366. [Google Scholar] [CrossRef]
- Radix, P.; Bastien, C.; Jay-Allemand, C.; Charlot, G.; Seigle-Murandi, F. The Influence of Soil Nature on Polyphenols in Walnut Tissues. A Possible Explanation of Differences in the Expression of Walnut Blight. Agronomie 1998, 18, 627–637. [Google Scholar] [CrossRef]
- Mikulic-Petkovsek, M.; Slatnar, A.; Veberic, R.; Stampar, F.; Solar, A. Phenolic Response in Green Walnut Husk after the Infection with Bacteria Xanthomonas arboricola pv. juglandis. Physiol. Mol. Plant Pathol. 2011, 76, 159–165. [Google Scholar] [CrossRef]
- McNeil, D.L.; Romero, S.; Kandula, J.; Stark, C.; Stewart, A.; Larsen, S. Bacteriophages a Potential Biocontrol Agent against Walnut Blight (Xanthomonas campestris pv. juglandis). N. Z. Plant Prot. 2001, 54, 220–224. [Google Scholar] [CrossRef]
- Hajri, A.; Meyer, D.; Delort, F.; Guillaumès, J.; Brin, C.; Manceau, C. Identification of a Genetic Lineage within Xanthomonas arboricola pv. juglandis as the Causal Agent of Vertical Oozing Canker of Persian (English) Walnut in France. Plant Pathol. 2010, 59, 1014–1022. [Google Scholar] [CrossRef]
- Chen, X.; Liu, H.; Dong, L.; Shi, J.; Ma, Z.; Yan, L.; Yin, Y. Identification and Characterization of Fusarium incarnatum Causing Leaf Spot and Fruit Rot on Luffa in China. Plants 2025, 14, 845. [Google Scholar] [CrossRef] [PubMed]
- Moisseyev, R.; Pozharskiy, A.; Taskuzhina, A.; Khusnitdinova, M.; Svanbayev, U.; Sapakhova, Z.; Gritsenko, D. Evaluation of Rz2 Gene Expression in Sugar Beet Hybrids Infected with Beet Necrotic Yellow Vein Virus. Curr. Issues Mol. Biol. 2024, 46, 11326–11335. [Google Scholar] [CrossRef] [PubMed]
- Gritsenko, D.; Daurova, A.; Pozharskiy, A.; Nizamdinova, G.; Khusnitdinova, M.; Sapakhova, Z.; Daurov, D.; Zhapar, K.; Shamekova, M.; Kalendar, R.; et al. Investigation of Mutation Load and Rate in Androgenic Mutant Lines of Rapeseed in Early Generations Evaluated by High-Density SNP Genotyping. Heliyon 2023, 9, e14065. [Google Scholar] [CrossRef]
- Kałużna, M.; Saux, M.F.-L.; Pothier, J.F.; Jacques, M.-A.; Obradović, A.; Tavares, F.; Stefani, E. Xanthomonas arboricola pv. juglandis and pv. Corylina: Brothers or Distant Relatives? Genetic Clues, Epidemiology, and Insights for Disease Management. Mol. Plant Pathol. 2021, 22, 858–869. [Google Scholar] [CrossRef]

| Location | Coordinates | Year | Disease | DI *, % | DSI **, % |
|---|---|---|---|---|---|
| Rural farm “Manshuk”, Almaty region | 43.257927° N 77.757149 ° E | 2023 | Walnut blight | 12 | 34 |
| 2024 | 13 | 36 | |||
| 2023 | Brown spot | 9 | 28 | ||
| 2024 | 11 | 33 | |||
| “Issyk State Dendrological Park” RSE, Almaty region | 43.455192° N 77.454092° E | 2023 | Walnut blight | 13 | 49 |
| 2024 | 14 | 50 | |||
| 2023 | Brown spot | 23 | 46 | ||
| 2024 | 26 | 51 | |||
| “Fazenda UM” LLP, Almaty region | 43.296643° N 77.383693° E | 2023 | Walnut blight | 13 | 36 |
| 2024 | 14 | 41 | |||
| “Saryagash zher syyi” LLP, Turkestan region | 41.492639° N 69.315194° E | 2023 | Walnut blight | 18 | 37 |
| 2024 | 22 | 50 | |||
| 2023 | Bacterial blight | 10 | 38 | ||
| 2024 | 13 | 42 | |||
| 2023 | Brown spot | 17 | 39 | ||
| 2024 | 19 | 39 | |||
| 2023 | Crown gall | 9 | 20 | ||
| 2024 | 8 | 15 | |||
| 2023 | Walnut canker | 10 | 20 | ||
| 2024 | 14 | 29 | |||
| “Silk alley” LLP, Turkestan region | 41.431411° N 69.112285° E | 2023 | Brown spot | 28 | 64 |
| 2024 | 30 | 70 | |||
| “Alma Arasan”, Almaty region | 43.102843° N 76.906788° E | 2023 | Walnut blight | 26 | 54 |
| 2024 | 26 | 57 |
| The Name of the Pathogen | Morphological Characterization |
|---|---|
| A. alternata | Isolates formed dark, grayish-black colonies with an olive tint and a characteristic white marginal ring on PDA. After 6 days, colony diameters ranged from 43.5 to 81.5 mm. Light microscopy revealed obclavate to obpyriform conidia arranged in chains of 6–14 elements, with 1–6 transverse and 0–3 longitudinal septa. Conidial dimensions were 16–40 × 4–13 µm. |
| F. incarnatum | Isolates formed colonies on PDA ranging in color from white to pale brown, characterized by abundant, floccose mycelium. Microscopic examination revealed characteristic macroconidia: slightly curved, with 3–5 septa, the apical cell pointed and slightly hooked, and the basal cell exhibiting a “foot-shaped” morphology. Mesoconidia of fusiform shape with 1–5 septa were also observed, as well as intercalary chlamydospores. |
| P. agglomerans | The isolated colonies of P. agglomerans grown on NA exhibited a yellow to cream pigmentation, were circular in shape, with a smooth, glossy surface and regular margins. Under light microscopy, the bacterial cells appeared as small Gram-negative rod-shaped structures. |
| X. arboricola pv. juglandis | The isolated colonies of X. arboricola pv. juglandis grown on NA were round, light yellow, with a smooth, glistening, and mucous surface, forming characteristic mucoid colonies. Under light microscopy, the bacterial cells appeared as rod-shaped structures. |
| A. tumefaciens | Colonies are round and milky-white to creamy, with smooth edges; the surface is smooth, slightly shiny, and moderately mucous. Under light microscopy, the bacterial cells appeared as Gram-negative, rod-shaped structures. |
| Species | Isolate/Strain | Accession Number | Median Read Length, bp | Mapped Reads |
|---|---|---|---|---|
| A. alternata | YICASTK5 | PP346363.1 | 367 | 8063 |
| F. incarnatum | ISPaVe 1946 | FN430680.1 | 355 | 6908 |
| P. agglomerans | CTN3 | HQ455830.1 | 288 | 6907 |
| X. arboricola pv. juglandis (listed as X. campestris in the NCBI) | USS-ML18 | PQ460288.1 | 321 | 2682 |
| A. tumefaciens | RB04 | PQ240107.1 | 318 | 8238 |
Disclaimer/Publisher’s Note: The statements, opinions and data contained in all publications are solely those of the individual author(s) and contributor(s) and not of MDPI and/or the editor(s). MDPI and/or the editor(s) disclaim responsibility for any injury to people or property resulting from any ideas, methods, instructions or products referred to in the content. |
© 2025 by the authors. Licensee MDPI, Basel, Switzerland. This article is an open access article distributed under the terms and conditions of the Creative Commons Attribution (CC BY) license (https://creativecommons.org/licenses/by/4.0/).
Share and Cite
Ismagulova, E.; Oleichenko, S.; Sarshayeva, M.; Korabayeva, S.; Nizamdinova, G.; Gritsenko, D.; Suleimanova, G.; Sapakhova, Z.; Basim, H.; Kairova, G. Identification, Characterization, and Pathogenicity of Fungal and Bacterial Pathogens of Walnut (Juglans regia L.) in Kazakhstan. Horticulturae 2025, 11, 1217. https://doi.org/10.3390/horticulturae11101217
Ismagulova E, Oleichenko S, Sarshayeva M, Korabayeva S, Nizamdinova G, Gritsenko D, Suleimanova G, Sapakhova Z, Basim H, Kairova G. Identification, Characterization, and Pathogenicity of Fungal and Bacterial Pathogens of Walnut (Juglans regia L.) in Kazakhstan. Horticulturae. 2025; 11(10):1217. https://doi.org/10.3390/horticulturae11101217
Chicago/Turabian StyleIsmagulova, Elmira, Sergey Oleichenko, Moldir Sarshayeva, Saule Korabayeva, Gulnaz Nizamdinova, Dilyara Gritsenko, Gulnur Suleimanova, Zagipa Sapakhova, Huseyin Basim, and Gulshariya Kairova. 2025. "Identification, Characterization, and Pathogenicity of Fungal and Bacterial Pathogens of Walnut (Juglans regia L.) in Kazakhstan" Horticulturae 11, no. 10: 1217. https://doi.org/10.3390/horticulturae11101217
APA StyleIsmagulova, E., Oleichenko, S., Sarshayeva, M., Korabayeva, S., Nizamdinova, G., Gritsenko, D., Suleimanova, G., Sapakhova, Z., Basim, H., & Kairova, G. (2025). Identification, Characterization, and Pathogenicity of Fungal and Bacterial Pathogens of Walnut (Juglans regia L.) in Kazakhstan. Horticulturae, 11(10), 1217. https://doi.org/10.3390/horticulturae11101217






